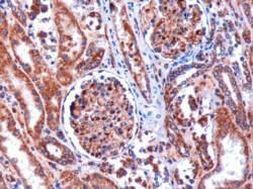
Kinesin 5B Antibody in Immunohistochemistry (Paraffin) (IHC (P))

Search
Invitrogen
Kinesin 5B Polyclonal Antibody
{{$productOrderCtrl.translations['antibody.pdp.commerceCard.promotion.promotions']}}
{{$productOrderCtrl.translations['antibody.pdp.commerceCard.promotion.viewpromo']}}
{{$productOrderCtrl.translations['antibody.pdp.commerceCard.promotion.promocode']}}: {{promo.promoCode}} {{promo.promoTitle}} {{promo.promoDescription}}. {{$productOrderCtrl.translations['antibody.pdp.commerceCard.promotion.learnmore']}}
图: 1 / 5
Kinesin 5B Antibody (PA1-31243) in IHC (P)





产品信息
PA1-31243
宿主/亚型
分类
类型
抗原
偶联物
形式
浓度
规格
保存条件
运输条件
RRID
产品详细信息
PA1-31243 detects KIF5B from human samples.
PA1-31243 has been successfully used in Western blot applications.
The PA1-31243 immunogen is: Synthetic peptide: QPVAVRGGGGKQV (Human) (C terminal).
Store product as a concentrated solution. Centrifuge briefly prior to opening the vial. For short-term storage (1-2 weeks), product can be stored at 4°C. For long-term storage, aliquot and store product at -20° C or below, avioiding multiple freeze-thaw cycles.
靶标信息
Microtubule-dependent motor required for normal distribution of mitochondria and lysosomes. Can induce formation of neurite-like membrane protrusions in non-neuronal cells in a ZFYVE27-dependent manner. Regulates centrosome and nuclear positioning during mitotic entry. During the G2 phase of the cell cycle in a BICD2-dependent manner, antagonizes dynein function and drives the separation of nuclei and centrosomes. Required for anterograde axonal transportation of MAPK8IP3/JIP3 which is essential for MAPK8IP3/JIP3 function in axon elongation.
仅用于科研。不用于诊断过程。未经明确授权不得转售。